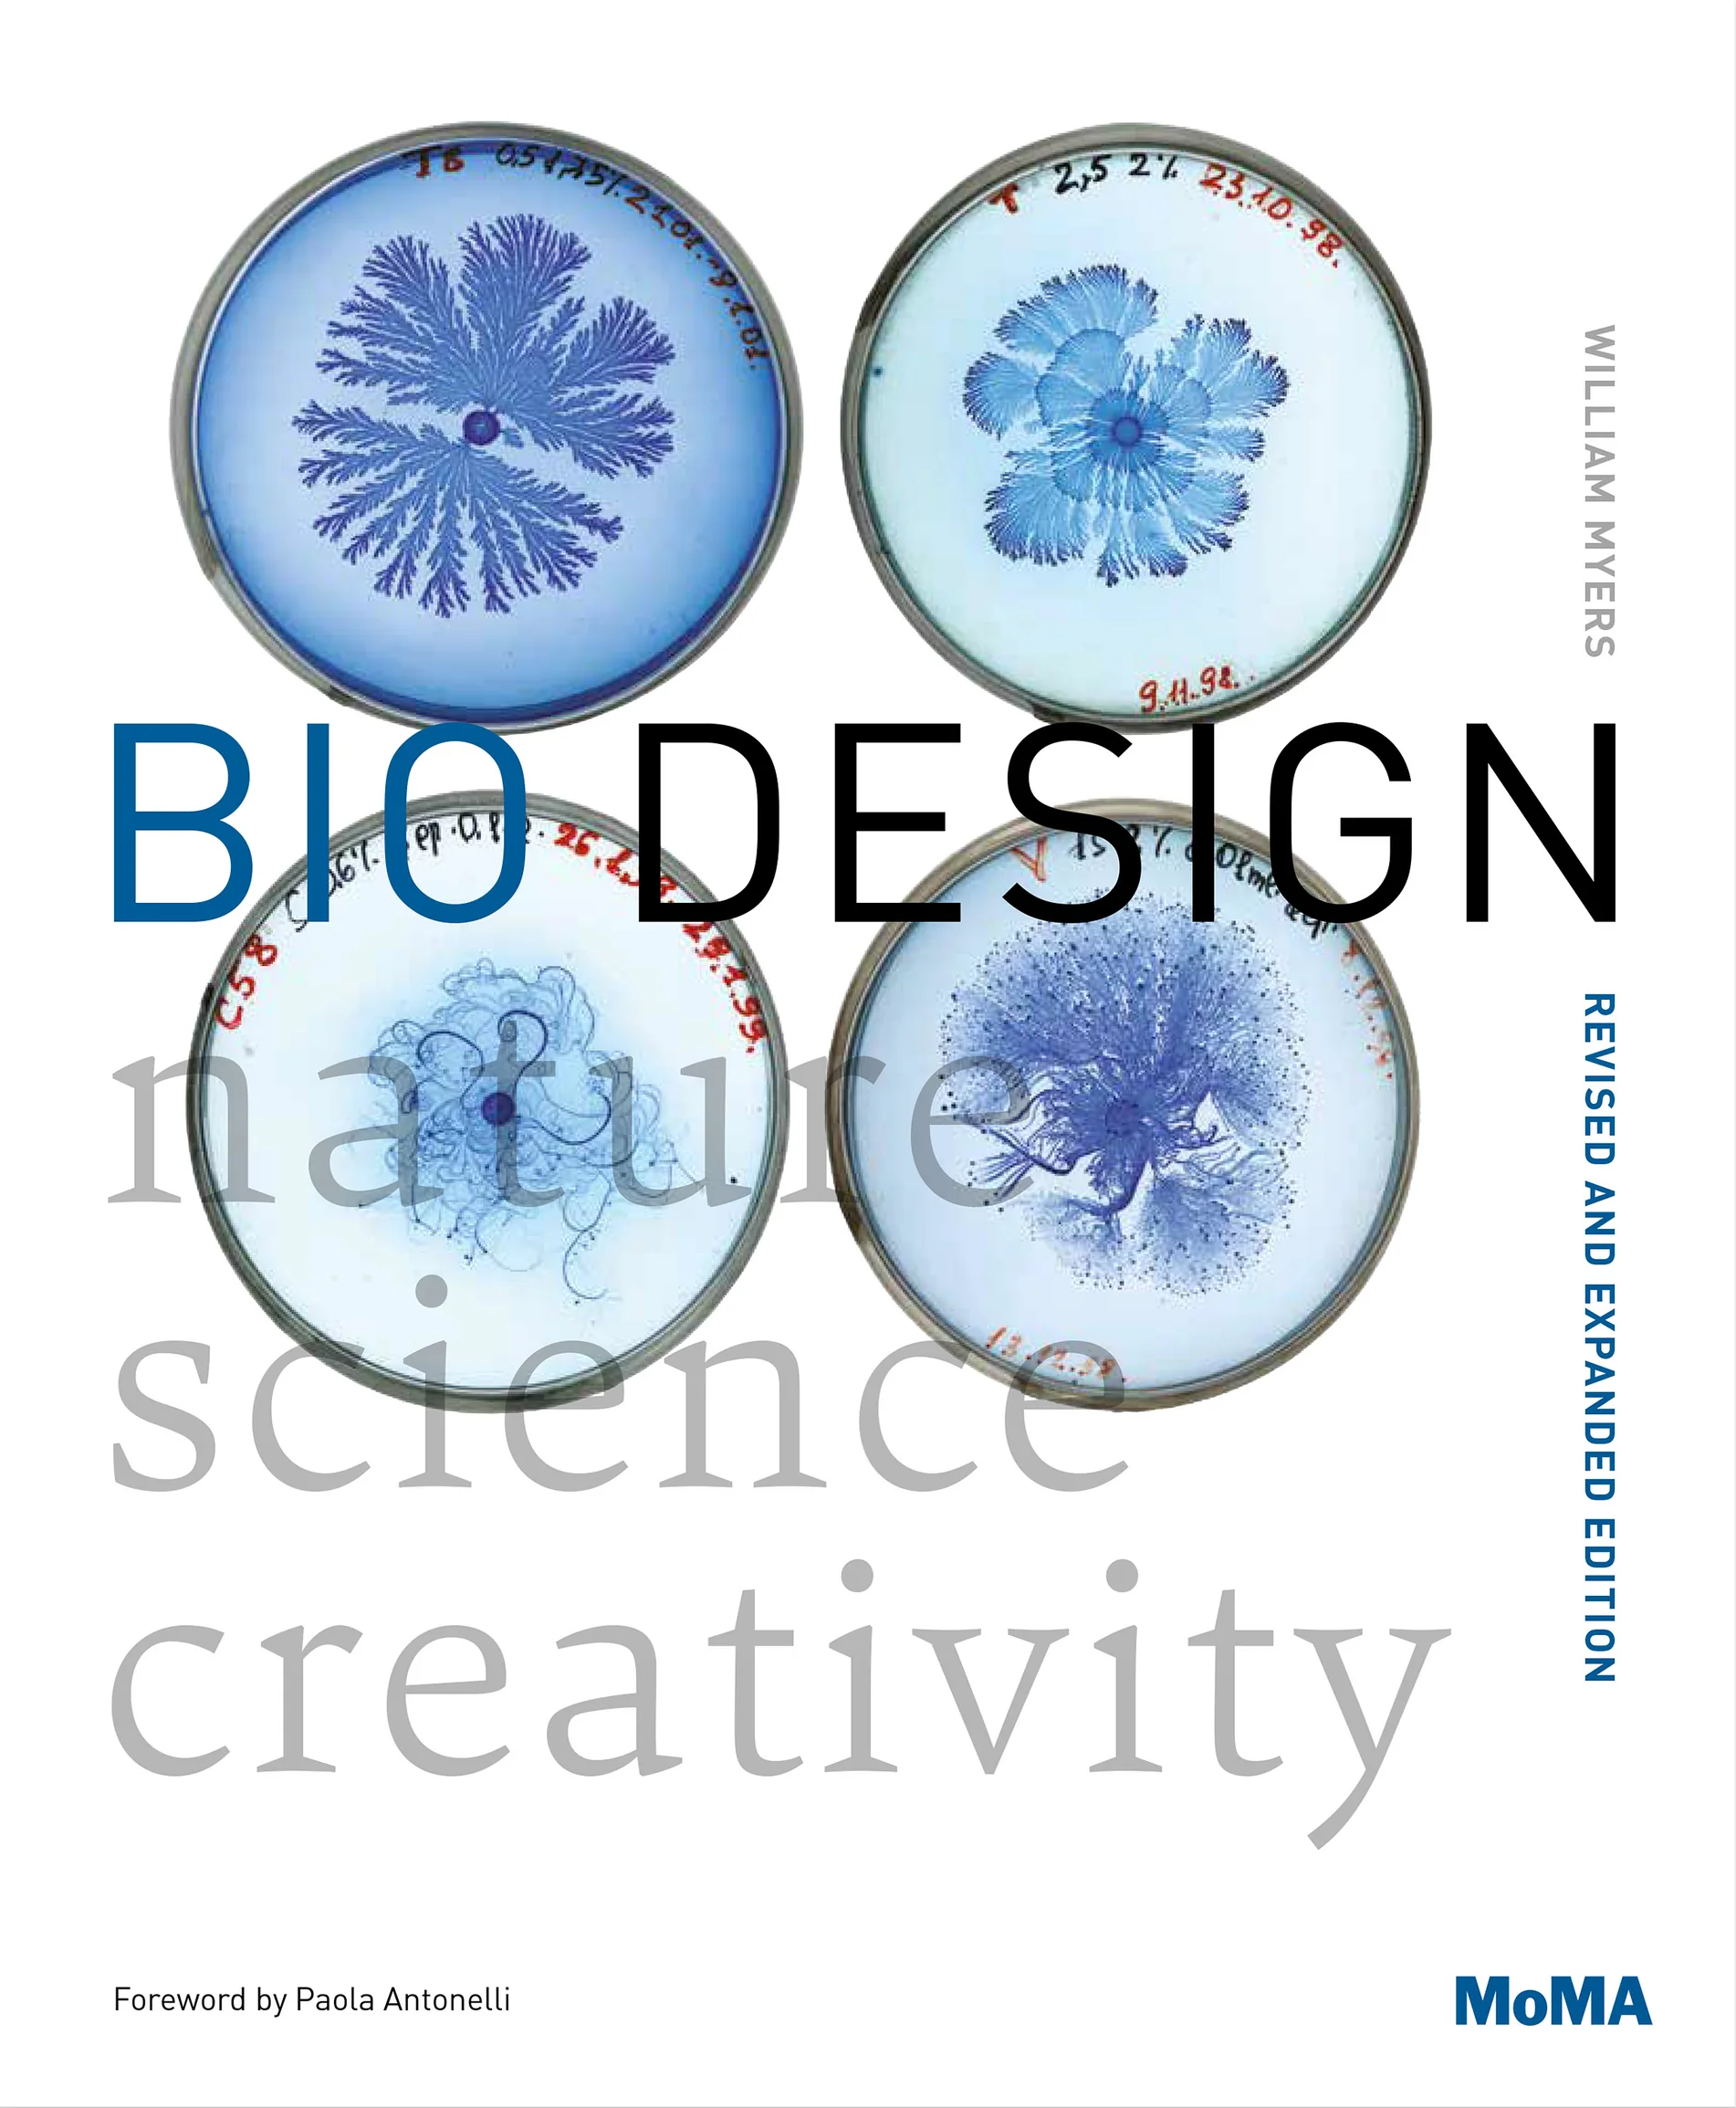
Bio Design: Nature + Science + Creativity,

Grow The Future: Visions of Biodesign

Bloom: From Food to Fuel, The Epic Story of How Algae Can Save Our World

Fungipedia

The Future is Fungi: How Fungi Feed Us, Heal Us, and Save Our World

Synthetic Aesthetics: Investigating Synthetic Biology’s Designs on Nature

The CHEMARTS Cookbook

Grow Magazine

Lo-Tek - Design by Radical Indigenism

Borne: A Novel

Bio Art: Altered Realities

Silent Spring

The Broken Earth Trilogy: The Fifth Season, The Obelisk Gate & The Stone Sky

Biomimetics for Designers: Applying Nature's Processes & Materials in the Real World

Finding the Mother Tree: Uncovering the Wisdom and Intelligence of the Forest

The Overstory

Radical Matter: Rethinking Materials for a Sustainable Future

A Rough Ride to the Future

The MaddAddam Trilogy: Oryx & Crake, The Year of the Flood & MaddAddam
Bio Design: Nature + Science + Creativity,


